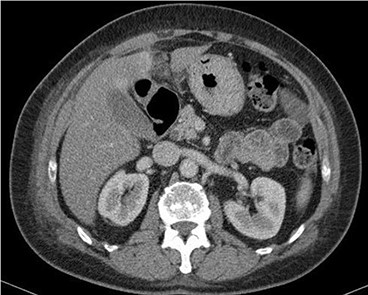
Contrast-enhanced CT scan shows a 32 × 22-mm oval-shaped fat density lesion with peripheral hyperattenuation and central hyperdense dot adjacent to falciform ligament. There is surrounding oedema and inflammation. Gall bladder is noted to be unremarkable. Features represent intraperitoneal focal fat infarction of fatty appendage of falciform ligament.

-
PDF
- Split View
-
Views
-
Cite
Cite
Adam O’Connor, Shariq Sabri, Maseera Solkar, Amaila Ramzan, Mamoon Solkar, Falciform ligament torsion as a rare aetiology of the acute abdomen, Journal of Surgical Case Reports, Volume 2022, Issue 1, January 2022, rjab150, https://doi.org/10.1093/jscr/rjab150
Close - Share Icon Share
Abstract
The falciform ligament is a remnant of the embryonic ventral mesentery containing the obliterated umbilical vein and round ligament. It extends from the umbilicus to the superior aspect of the diaphragm. We report about a 53-year-old fit and well patient who presented with acute upper abdominal pain with tenderness to palpation. Ultrasound scan was unremarkable, but blood tests revealed raised inflammatory markers. Thus, computed tomography was performed. This demonstrated acute torsion and fat necrosis of the falciform ligament, which was the aetiology of the upper abdominal pain. Such pathology is rare with 23 previously reported cases. Conservative management is usually proposed, but on occasion, surgical intervention may be warranted in cases that do not respond to initial supportive measures. We describe this case to demonstrate a rare cause of a common presentation to the surgical service.
INTRODUCTION
The falciform ligament is a double-fold of peritoneum separating the right and left liver lobes. It is a remnant of the ventral embryonic mesentery containing the obliterated umbilical vein and round ligament, extending from the umbilicus to the superior aspect of the diaphragm. Pathological processes affecting the falciform are rare. We describe an acute torsion of the falciform ligament leading to fat necrosis and development of an acute abdomen. Indeed, only five adult cases of such a pathology have been identified on CT scan [1].
CASE REPORT
A 53-year-old fit and well woman presented to the emergency department with acute epigastric and right hypochondrium pain with a positive Murphy’s sign of the abdomen. The patient was anicteric and apyrexial. Blood tests performed revealed a white cell count of 13.6 × 109/L and a C-reactive protein of 110 U/L. Liver function tests, amylase and urea and electrolytes were unremarkable. A working diagnosis of acute cholecystitis was made and the patient commenced on intravenous fluids and intravenous antibiotics. Abdominal ultrasound was performed, which demonstrated no gallstones nor choledocholithiasis and was essentially normal. Given the raised inflammatory markers and persistent abdominal pain, CT scan was performed (Fig. 1). This revealed a 32 × 22-mm oval-shaped fat density lesion with peripheral hyper attenuation adjacent to the falciform ligament, representing intraperitoneal focal fat infarction of the fatty appendage of falciform ligament. Sagittal reconstruction showed a central hyperdense thrombosed vessel secondary to torsion of the falciform ligament (Fig. 2).
Contrast-enhanced CT scan shows a 32 × 22-mm oval-shaped fat density lesion with peripheral hyperattenuation and central hyperdense dot adjacent to falciform ligament. There is surrounding oedema and inflammation. Gall bladder is noted to be unremarkable. Features represent intraperitoneal focal fat infarction of fatty appendage of falciform ligament.

Sagittal reconstruction redemonstrates central hyperdense thrombosed vessel secondary to torsion
The patient was managed conservatively with continuation of the intravenous antibiotics and appropriate analgesia. The patient recovered well with resolution of all blood tests to within normal limits. They were discharged on day 7. Follow-up clinic review was performed at 6 weeks by which time all symptoms had resolved without recurrence. To date, no further episodes of pain have been reported by the patient.
DISCUSSION
Falciform ligament pathology is rare. Known pathologies include cysts, tumours, varices, internal herniation, fat necrosis related to acute haemorrhagic pancreatitis as well as torsion of the fatty appendage of the falciform as described in our case [2].
Intra-abdominal focal fat infarction is a previously described phenomenon whereby focal fat necrosis occurs in a variety of different anatomical regions [3]. Such locations can include the greater omentum, appendices epiploica and fatty appendage of the falciform ligament [3]. They are rare diagnoses, and thus are often mistaken for other diseases, such as acute appendicitis or acute cholecystitis. Blood tests are non-specific but often reveal slightly raised inflammatory markers as found in the aforementioned differential diagnoses [4]. CT scan is the gold standard for diagnosis, with an area of higher fat density with surrounding inflammatory fat stranding around the falciform planes being diagnostic of acute torsion of the fatty appendage of the falciform ligament [5].
There have been in the region of five torsions of fatty appendage of the falciform ligament that have been diagnosed on CT scan imaging and reported in adult patients [1]. Most presentations in adults present with right hypochondrium pain and epigastric pain with mild elevations in inflammatory markers on blood tests. Most cases involved diagnostic confirmation via laparotomy or laparoscopy [1]. However, further studies into intra-abdominal focal fat infarction have resulted in recommendations to treat such conditions with conservative treatment and supportive care [6]. In particular, radiologists who recognize the unique features of this pathological process as in our case can help to prevent unnecessary surgical intervention.
Undoubtedly, a rare pathology, torsion of the fatty appendage of the falciform ligament can mimic many other upper abdominal conditions. Nevertheless, its unique yet subtle features on CT scan can contribute to its early diagnosis. Given the optimum management is with supportive care, consideration of such a differential can prevent unwarranted laparotomy or laparoscopy in such patients.
AUTHORS’ CONTRIBUTION
All authors contributed to formulation and writing of the manuscript, along with subsequent revisions.
CONFLICT OF INTEREST STATEMENT
No conflict of interest.
FUNDING
No funding was received for this report.
CONSENT
Patient consent was obtained and consent form available upon request.